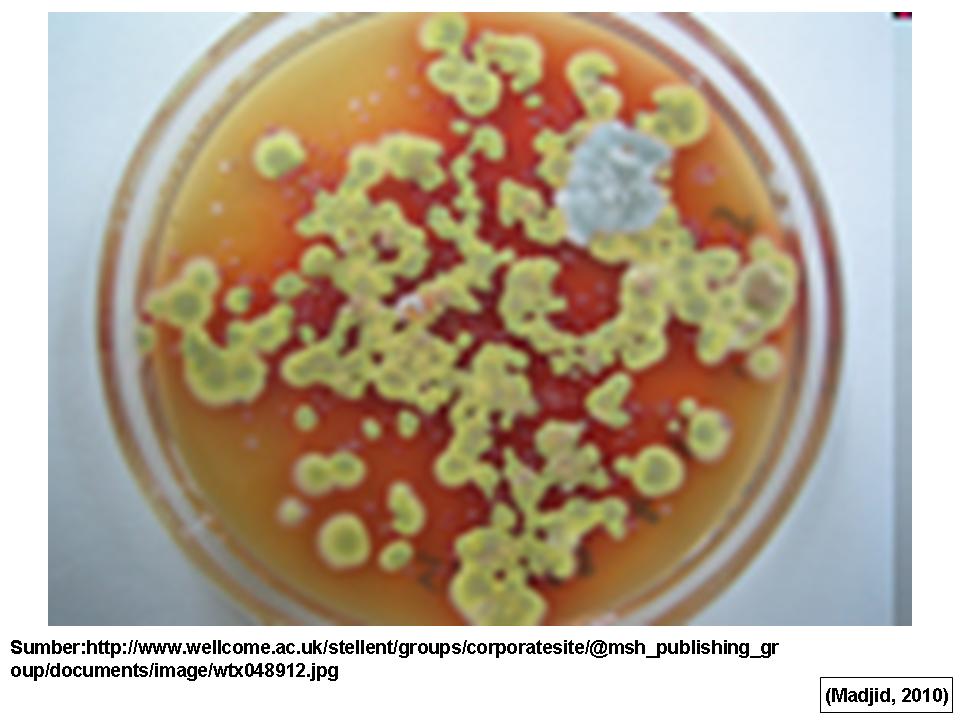

Плесневые грибы-аллергены: Визуальный обзор

Раздел: Природная галерея